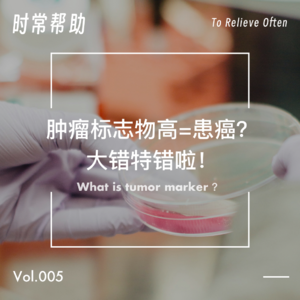
Vol.5 肿瘤标志物升高＝患癌？肿瘤标志物正常就万事大吉？大错特错啦！

拿到健康体检报告,你最关心的项目会是什么呢?是不是和主播西西一样,会第一时间去看肿瘤标志物?西西说她每当看到肿瘤标志物都正常,悬着的心就放下了大半——她一直认为肿瘤标志物正常就不会有大问题。
实际上这样的想法是错误的:肿瘤标志物并不能很好地筛查癌症,肿瘤标志物都正常也不代表绝对没有患癌。
那么今天一起来了解肿瘤标志物究竟是什么,以及该如何正确使用吧~
【时间轴】
3:37有些肿瘤标志物是会少量存在于健康人群体内的
12:50由于癌症的异质性,并不存在百试百灵的肿瘤标志物
16:05美国“滴血验癌”的骗局
23:11只有两种早期癌症能通过肿瘤标志物筛查出来
35:21在癌症诊疗的临床实践中,肿瘤标志物的作用是后置的
36:22如果体检发现肿瘤标志物升高了该如何应对
44:40症状更重要,千万不能因为肿瘤标志物数值正常就选择性无视症状,会延误病情
【参考资料】
[1] 曾用「滴血验癌」狂骗 90 亿,还逼死了一位学术大佬,时隔 6 年她终被定罪,面临 20 年刑期mp.weixin.qq.com
[2] 中国抗癌协会肿瘤标志专业委员会.中国人群肺癌血清标志物临床应用及参考区间建立规范化流程专家共识[J].中国肿瘤临床,2021,48(22):1135-1140.DOI:10.12354/j.issn.1000-8179.2021.20211020.
【聊天的人】马扬、西西
【特别感谢】璐站对检验学相关描述的勘误
【片头曲】Natrual Ability by 鹤The Crane
【片尾曲】男人也好女人也好 by 张信哲
【平面设计】不知心
【收听方式】小宇宙app、苹果播客、喜马拉雅、荔枝FM、网易云音乐、QQ音乐、蜻蜓FM、豆瓣app等平台均可搜索“时常帮助”收听到本节目
【关注我们】微信公众号:时常帮助